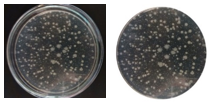
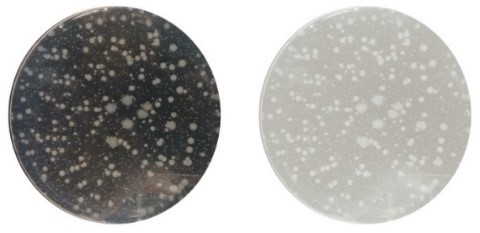

Resumen: Este artículo plantea el diseño e implementación de una aplicación móvil que mediante un sistema de visión por computadora permite realizar el conteo de colonias de bacterias en cultivos microbianos disminuyendo significativamente el tiempo de la cuantificación y generando un método estándar de conteo para dispositivos móviles con sistema operativo Android. Así como un simulador de colonias de bacterias que permite generar muestras controlando parámetros de crecimiento de bacterias con el fin de ayudar a probar la eficiencia de la aplicación de conteo de colonias de bacterias.
Palabras clave:AndroidAndroid,aplicación móvilaplicación móvil,conteo microbiológicoconteo microbiológico,visión por computadoravisión por computadora.
Abstract: This article proposes the design and implementation of a mobile application using a computer vision system that allows counting bacterial colonies in microbial cultures, decreasing significantly the time of quantification and generating a standard counting method for mobile devices running Android OS. As well as a bacterial colony simulator that allows generating samples controlling bacterial growth parameters in order to help to test the efficiency of the bacterial colony count application.
Keywords: Android, Mobile Application, Microbiological Counting, Computer Vision.
Computación e Informática
Simulación y Conteo de Unidades Formadoras de Colonias.
Simulation and Counting of Colony-Forming Units.

Recepción: 28 Agosto 2016
Aprobación: 12 Marzo 2017
El área microbiológica forma parte de las actividades cotidianas, diariamente los microorganismos los encontramos participando de manera benéfica y perjudicial, desarrollando diferentes papeles. En el área biológica, una de las tareas es el aislamiento y la identificación. Dependiendo del tipo de muestra y análisis es necesario conocer el número de unidades formadoras de colonias (UFC) presentes, este número es tomado en cuenta para cumplir los estándares establecidos bajo normatividad en el área de los alimentos, en el área de salud, análisis de agua, aire y suelo entre otros. Para estos análisis los expertos de estas áreas realizan conteos manuales o muy rudimentarios que consumen grandes cantidades de tiempo con resultados que varían según quien realice el conteo.
Este trabajo de investigación se ha planteado para el área de los alimentos debido a que, a pesar de ser una fuente de nutrientes, a menudo constituyen un medio de cultivo ideal para la multiplicación microbiana. Desde el punto de vista sanitario, los alimentos pueden ser vehículos de infecciones o de intoxicaciones graves, provocando las Enfermedades Transmitidas por los Alimentos (ETA) que constituyen un gran problema de salud pública.
De acuerdo a la importancia de estos microorganismos causantes de importantes ETA, los laboratorios se ven en la necesidad de aplicar distintas técnicas para el aislamiento y conteo de microorganismos presentes en los alimentos, sin embargo, para la identificación se tienen que realizar pruebas con múltiples muestras, estos procedimientos de rutina suelen consumir mucho tiempo y reactivos ya que para la identificación los microorganismos se deben sembrar en varios medios de cultivo para distinguir la bacteria de interés y realizarse por duplicado o triplicado para obtener una mayor confiabilidad en los resultados.
En este trabajo se propone un simulador de colonias de bacterias con el fin de controlar algunos parámetros que afectan al crecimiento de las bacterias, para así generar imágenes de muestras controladas y realizar pruebas utilizando una aplicación móvil para automatizar la cuantificación de colonias de bacterias en placas de cultivo mediante un sistema de visión por computadora, en el que se recorta la imagen, se convierte a escala de grises, se mejora el contraste y se segmenta la imagen para poder realizar el conteo.
Para estudiar las características físicas, químicas y fisiológicas de una bacteria, se necesita que ésta sea aislada en cultivo puro, y el aislamiento en caja Petri es el primer paso para ello. Una vez que ha sido preparado un medio de cultivo, puede ser utilizado para ser inoculado y a continuación incubado en condiciones que favorezcan el crecimiento microbiano. Existen varias técnicas para lograr el aislamiento bacterias, las más utilizadas son Estría Cruzada, Diluciones, Vaciado en Placa y Extensión por Varilla.
Los nutrientes requeridos por las bacterias que se cultivan se encuentran contenidos en los medios de cultivo. Los medios de cultivo son las soluciones nutritivas que se utilizan en el laboratorio para el cultivo de microorganismos.
La NOM-065-SSA-1993 que establece las especificaciones sanitarias de los medios de cultivo, los clasifica de acuerdo a su uso (Diario Oficial de la Federación, 1995):
Medios Selectivos
Medios Selectivos por Enriquecimiento
Medios Diferenciales
Las colonias de bacterias que se obtienen mediante el uso de estas técnicas en estos medios pueden ser estudiadas en cuanto morfología colonial, identificación, crecimiento y actividad metabólica de la bacteria.
Cuando se desea cuantificar el número de bacterias presentes en múltiples muestras, los procedimientos de rutina suelen consumir mucho tiempo. En ese periodo las muestras podrían sufrir modificaciones en su población (Corral-Lugo, 2012).
La cuantificación de microorganismos es un elemento crítico en los estudios de ecología microbiana y microbiología clínica. No solo es importante conocer al responsable de un efecto benéfico o identificar al microorganismo potencial de causar alguna infección severa, sino también es importante saber el número de microorganismos implicados, para establecer si éstos serán capaces de desarrollar una función benéfica o perjudicial (Corral-Lugo, 2012).
Existen diferentes tipos de métodos o técnicas para la cuantificación de microorganismos, las cuales se describen a continuación:
Consiste en realizar diluciones seriadas 1:10 y extender 0.1 mL de cada dilución en una placa; las placas se incuban hasta que las colonias son apreciables para su recuento. Esta metodología tiene la ventaja de tener un buen límite de detección, sin embargo consume mucho tiempo durante los plaqueos; en el caso de realizar el recuento de bacterias a partir de muestras cuya población se desconoce se requiere realizar el extendido de siete diluciones y la muestra original (para cada conteo) lo que significa consumir ocho placas de cultivo y alrededor de 25 minutos para los plaqueos, sin tomar en consideración repeticiones (Ortega Olguín, 2014).
La norma oficial mexicana NOM-092-SSA1-1994, Bienes y Servicios. Método para la cuenta de bacterias aerobias en placa (Diario Oficial de la Federación, 1995) sugiere utilizar las siguientes herramientas para el conteo de colonias de bacterias:
Contador de colonias de campo obscuro, con luz adecuada, placa de cristal cuadriculada y lente amplificador: Está diseñado para el conteo rápido y preciso de las colonias de bacterias y moho en placas de cultivo. Permite el conteo de las colonias por cada pulsación del contador quedando grabado en la pantalla digital.
Registrador mecánico o electrónico: Combina la función de contador electrónico por presión, con el marcaje mediante el marcador indeleble, impidiendo un doble conteo.
Es un sistema de siembra todo-en-uno. Los ingredientes varían de una placa a otra dependiendo de los microorganismos de interés. En lugar de una placa de Petri, Petrifilm hace uso de película de plástico delgada como soporte del medio de cultivo, generalmente, comprende un agente gelificante soluble en agua fría, los nutrientes y los indicadores para la actividad y la enumeración. Después de la incubación, las colonias típicas se pueden contar ya sea manualmente (facilitado por la rejilla en el fondo de la película y de colonias de color característico) o automáticamente (Ortega Olguín, 2014).
El propósito del simulador de colonias de bacterias es generar imágenes controladas de bacterias. Este simulador es una aplicación de escritorio que ayuda a realizar las pruebas de eficiencia de la aplicación de conteo automático de colonias de bacterias.

La Figura 1 describe el funcionamiento general del simulador de colonias de bacterias. Para generar una muestra se deben obtener los siguientes parámetros de simulación:
Número de colonias de bacterias
Número de muestras (imágenes) a simular
Medio de Cultivo
Bacterias
Con el propósito de hacer una simulación más cercana a la realidad, se seleccionaron cuatro de las bacterias más patógenas de los alimentos, esto porque son microorganismos muy utilizados en laboratorios de microbiología y las características morfológicas de las colonias de estas bacterias no son muy parecidas entre sí. Las bacterias utilizadas en el simulador de colonias de bacterias son las siguientes:
Escherichia coli
Salmonella typhimurium
Staphylococcus aureus
Bacillus cereus
Las características morfológicas más representativas de las bacterias Las características seleccionadas son las siguientes:
Color
Tamaño
Dentro del área de microbiología existen diferentes tipos de medios de cultivo para diferentes tipos de pruebas con distintos microorganismos.
Dichas características cambian según el medio de cultivo en el que se encuentra la bacteria por lo que éste es fundamental para realizar la simulación de manera exitosa, así que este simulador de colonias de bacterias sólo trabaja con dos tipos de medio de cultivo:
Medios Selectivos: Contienen sustancias que impiden el desarrollo de algunos microorganismos, pero en una flora mixta permiten el aislamiento y recuperación del germen o grupo de gérmenes de interés
Medios diferenciales: Contienen indicadores de ácido base, redox o sustancias que detectan cambios en el medio o en las características típicas de la colonia.

En la figura 2 se observan diferentes muestras simuladas, las cuales son imágenes de 300x300 en formato PNG. Las colonias de bacterias se generan de manera aleatoria y verificando que éstas no se sobrepongan entre sí dentro de una elipse, simulando la caja Petri, esto con el fin de ayudar a la aplicación de conteo al momento de recortar la foto y obtener el número de UFC presentes en la muestra.
La aplicación se puede ejecutar en dispositivos móviles con las siguientes características mínimas:
Sistema operativo Android versión 4.1+
Memoria RAM de 1Gb
Procesador 1.2GHz


En la figura 4 se muestra el diagrama del proceso de adquisición de la imagen de la aplicación, donde se muestra cómo el dispositivo toma la imagen y la digitaliza en RGB para un futuro pre-procesamiento.
Con el afán de contribuir a que la aplicación logre resultados satisfactorios en la etapa de conteo de colonia de bacterias, se diseña e implementa una etapa de pre-procesado de las imágenes, el objetivo principal es generar un acondicionamiento para reducir el nivel de ruido y aumentar las posibilidades de un conteo exitoso. Por otra parte, una desventaja clara es la variedad de capacidades de procesamiento que presentan hoy en día los dispositivos móviles, es por eso que el procesamiento tiene que ser diseñado de la mejor manera para que pueda ser ejecutado por la mayoría de los dispositivos.
Dicha etapa consiste en la aplicación ordenada de algoritmos de filtrado y mejoramiento de imágenes existentes, donde cada uno de ellos cuenta con un objetivo bien definido.
Descripción del Pre-procesado de la imagen.
El acondicionamiento de la imagen es realizado en 4 etapas: recorte, filtrado, mejoramiento y segmentación. En la Tabla 1 se explica cómo se realiza cada una de las etapas







A continuación, se presentan los resultados de los conteos de colonias de bacterias a partir de muestras generadas en el simulador de colonias alcanzados con la aplicación propuesta y las siguientes dos aplicaciones de conteo seleccionadas en el mercado (Tabla 2):

La Figura 11 muestra diez imágenes generadas con el simulador de colonias de bacterias de una muestra mixta de las bacterias Escherichia coli y Salmonella typhimurium. Las primeras cinco muestras son en medio de cultivo EMB y las restantes en medio de cultivo Verde Brillante.

Los resultados alcanzados al hacer los conteos automáticos con las aplicaciones mencionadas anteriormente se muestran en la Tabla 3:

Se pueden observar en la Tabla 3 los resultados del conteo de las aplicaciones de los cuales se obtuvo el porcentaje de eficiencia en los conteos para cada una de ellas de la siguiente manera:
Porcentaje de Eficiencia

Donde:
n es el número de muestras selecionadas
Porcentaje de Perdida de UFC
Teniendo que la aplicación propuesta tiene un porcentaje de efectividad de conteo del 98%, la aplicación APD Colony Counter del 32% y la CFU Scope del 46%.
Lo que permite establecer que la aplicación propuesta obtiene el mejor resultado de efectividad, por lo que el procesamiento de la imagen y el algoritmo de conteo de la aplicación propuesta es eficiente.
Un buen pre-procesamiento en la imagen funge un papel muy importante dentro de la aplicación, ya que este ayuda a tener mejores resultados que si se procesara la imagen tal y como se obtiene en la etapa de adquisición.
La aplicación móvil puede trabajar en cualquier laboratorio de microbiología gracias a que sigue las normas y estándares con las que se rigen los laboratorios al momento de trabajar con cultivos en placa.
Estas muestras simuladas no pretenden sustituir las muestras experimentales, ya que al momento de trabajar en un laboratorio de microbiología existen infinidad de variables que pueden afectar al comportamiento y crecimiento de los microrganismos.
Las simulaciones sólo se utilizaron para realizar las pruebas de efectividad de los algoritmos de la aplicación.